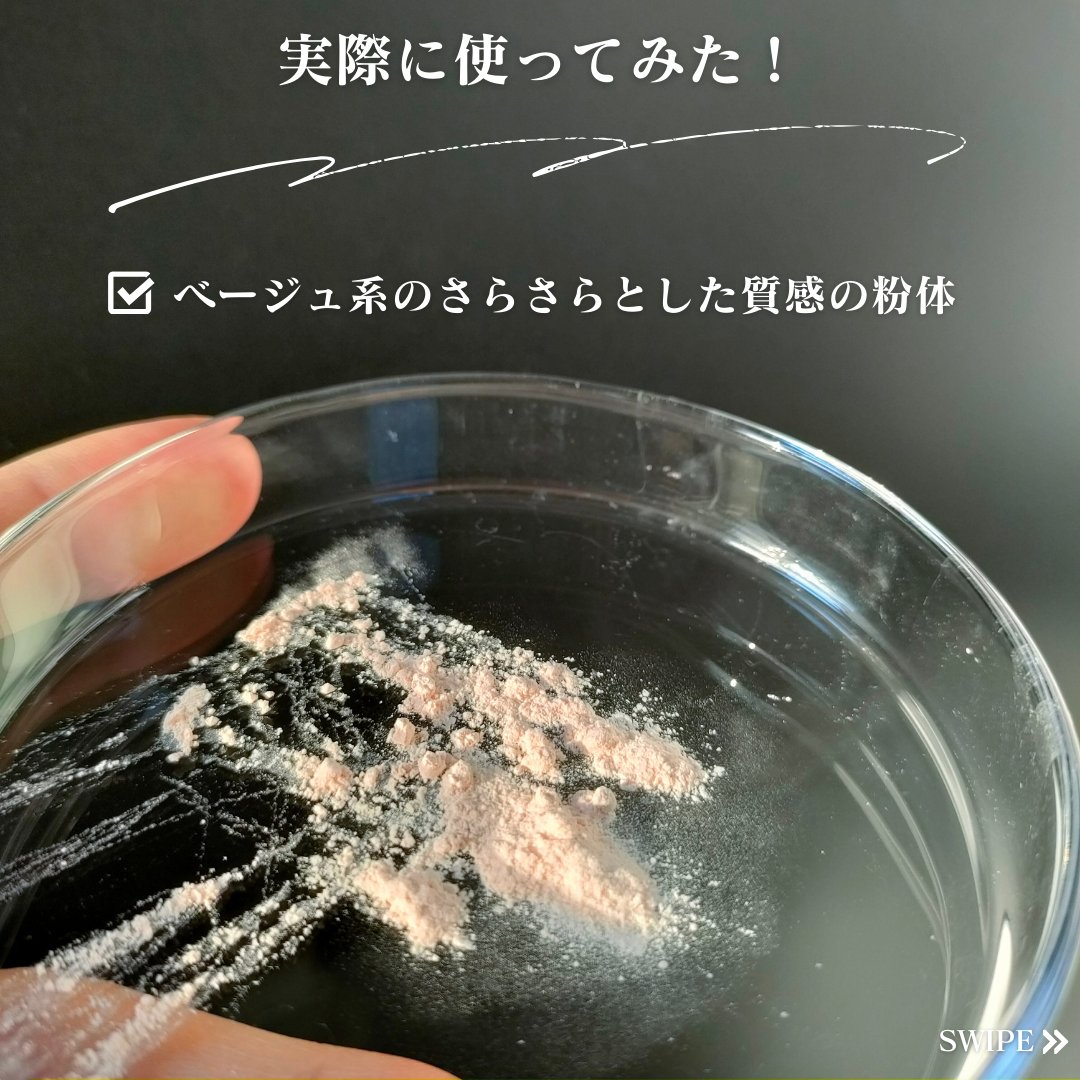

#gifted#スターオブザカラースクリーンに映る俳優さん達を美しくみせるアイテムとして、撮影用に生まれたベースメイク専門ブランド【STAROFTHECOLOR】様の商品をお試しさせていただきました𓂃꙳"ワセリンファンデ"とも呼ばれるクリーム...
もっと見るルースパウダーランキング
| 商品画像 | 商品情報 | 参考価格 | 評価 | ランキングIN | 特徴 | 商品リンク |
|---|---|---|---|---|---|---|
SHISEIDO SHISEIDO エッセンス スキンセッティング パウダー | 5,500円 |
| フェイスパウダーランキング第2位 | パウダーが軽いのでほんとつけていることを 忘れてしまうような薄膜感な仕上がりでした | 詳細を見る | |
DECORTÉ ルース パウダー | 6,270円 |
| フェイスパウダーランキング第4位 | とにかくお粉がふわっふわでサラサラで良い❤️ | 詳細を見る | |
JILL STUART グロウシフォン ラスティング ルースパウダー | 5,280円 |
| フェイスパウダーランキング第6位 | 詳細を見る | ||
GIVENCHY プリズム・リーブル | 8,250円 |
| フェイスパウダーランキング第5位 | パール配合でツヤっとした肌に✨ナチュラルなんだけど品があってこのツヤがとってもキレイなの🥺 | 詳細を見る | |
クレ・ド・ポー ボーテ プードルトランスパラントn | 13,200円 |
| フェイスパウダーランキング第9位 | 粉の繊細さが増したと感じられファンデーションで作ったつや肌もきちんと残してくれて 「めちゃくちゃ良い…!」と心が躍りました♪ | 詳細を見る | |
DECORTÉ フェイスパウダー | 5,500円 |
| フェイスパウダーランキング第14位 | 溢れ出るツヤ感がとっても綺麗で、透明感のある仕上がりに◎ふわりサラリと軽やかな触り心地! | 詳細を見る | |
THREE アドバンスドエシリアルスムースオペレーター ルースパウダー | 6,050円 |
| フェイスパウダーランキング第15位 | お肌にのせた瞬間、 存在感を放ちます…! 一気に毛穴が目立たなくなるんです‼️ | 詳細を見る | |
CEZANNE シームレスカバーパウダー | 968円 |
| フェイスパウダーランキング第17位 | 隙なしお肌が好きな人にこれはウケる。塗った後の毛穴の隠れ方がすごいから。 | 詳細を見る | |
GUERLAIN メテオリット ビーユ | 10,120円 |
| フェイスパウダーランキング第19位 | まぁるい6色のカラーパールがコロコロとぎっしり♡ブラシでくるくる粉を取るだけで丁寧に作り込んだ肌に! | 詳細を見る | |
excel エクストラリッチ セラムインパウダー | 2,640円 |
| ベースメイクランキング第150位 | パフは肉厚でリッチな使用感。 ふわふわで肌あたりも良くて贅沢な使い心地..✨ パウダーは粒子が細かくてふわふわ! | 詳細を見る |
pepe_mensbeautyさんの人気クチコミ
めちゃくちゃナチュラルに見えるのに、肌が本当に綺麗に見える! ラメがほんの少し入ってるけど、メンズでも気にならない程度で良き。 今までのオールインワン下地系で、今年の個人的ベスコスに絶対に入る! 妻と毎日のように愛用してるので、実はもうこれ2本目!笑 もう1本予備欲しいのですが、今店頭で売り切れてて買えない… 次見かけたら、ストック絶対買う!! メンズも使いやすいし、彼女や奥さんとシェアもしやすいので是非買ってみて!!
もっと見る
256
35
- 2023.10.18
しゃばしゃばした化粧水なので、さっぱり感抜群! 肌の赤みへの効果はあるので鎮静される感覚があります! ドクダミエキが77%配合されていることは、もちろんGOODポイントで、その他にも、抗炎症成分のツボクサエキス(CICA成分)や組織修復成分のパンテノールが配合されているのもGOODポイントです!
もっと見る
189
11
- 2022.11.27
今回は、前回に引き続き、MENSNULLから23年4月に発売された『フェイスパウダー』について紹介していきます!こちらの商品は、日中のテカり・べたつき・化粧崩れ・メイクのマスク移りなどを防止してくれるフェイスパウダーです!男性へのオススメポイ...
もっと見る
165
14
- 2023.07.23
2種の有効成分で「ニキビケア」と「美白ケア」ができる! EPCと呼ばれる成分で、皮脂抑制効果などによるニキビケア・毛穴ケアができる! 男性にこそぴったりな化粧水です! 浸透感抜群で、めんどくさがりな男性でも使いやすい! さらっとした使用感なのに保湿感もしっかりある! 重要な成分「EPC」が入っていたり、層状ナノカプセル技術※が使われていたりとプチプラでは出せない要素がしっかり詰まっています! 成分・使用感で見ても、他の化粧水とは明らかにワンランク上ですので まだ使ったことがない方はは是非お試し下さい!
もっと見る
163
12
- 2023.04.17
1つで6役なので、朝の洗顔後のスキンケアはこれだけでOK! 化粧水・美容液・乳液・クリーム・日焼け止め・トーンアップ効果! 塗り広げた後もべたつき・テカり無し ジェル状でムラなく伸ばせるので使いやすい! べたつきやテカりもないので、スキンケア初心者の方でも非常に使いやすいと思います! ただ、正直、トーンアップ効果は全く感じません! それ以外はすごくいいと思います! スキンケアを始めるならこのアイテムから始めることをオススメします! 是非気になる方はお試し下さい!
もっと見る
158
13
- 2023.04.19
NULLの方がVIOにも使用することができ、公式HPから購入すると全額返金保証があるので、オススメです! 初めて除毛クリームを試すなら、NULLが良いかも? 除毛後は肌が非常に敏感になっているので、化粧水や乳液・クリームでしっかりと保湿ケアするのを忘れないようにしてあげてください! グリチルリチン酸ジカリウムなどの抗炎症成分が入っているものだと尚良しです!
もっと見る
155
16
- 2023.07.14
![LIPS[リップス] - コスメのクチコミ検索アプリ](https://cdn.lipscosme.com/assets/lips_logo_full_2022-bc7b4bc9dd66035bc5696b0d16bc3d38a7be357186656c039e68cc4cf21ae675.png)

コメント